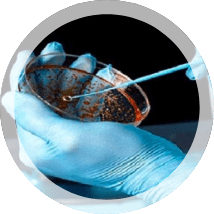
control de contaminación (industrial)

Mantenga la
calidad del aire interior
verificado por AGORA'S
Bienvenidos a AGORA'S Service Group
AGORA'S cuenta con
- El conocimiento sobre las tendencias e iniciativas de la calidad del aire interior.
- Un servicio de excelencia garantizado con equipos de última generación.
- Técnicos capacitados y certificados para ofrecer una calidad del aire interior (CAI) proactiva.
- Un servicio preciso a través de tarifas competitivas.
- Un entorno de trabajo en cumplimiento.
- Integridad de servicio a través de la confianza y la colaboración.

Nuestro personal está entrenado en las siguientes áreas
- Consultas sobre la calidad del aire interior
- Limpieza y desinfección de conductos de aire acondicionado
- Estudios ambientales
- Microbiología industrial
- Remediación de moho
- Restauración de incendios
- Evaluaciones HVAC
Visión
Ser la empresa consultora preferida para las soluciones de calidad del aire interior, brindar el mejor servicio y asegurar el pleno cumplimiento de requisitos mientras superamos los objetivos y compromisos de cada cliente.
Misión
Brindar el apoyo de asociación más completo y competente en el negocio de la calidad del aire interior. Crear programas de seguimiento integrales y habituales para satisfacer las necesidades del cliente. También nos esforzamos por apoyar la iniciativa verde para asegurar que nuestro cliente logre sus metas, cumpla con los requisitos y proporcione el ambiente de trabajo adecuado a sus asociados.
La Limpieza de Conductos es
Nuestro Negocio
AGORA'S Indoor Air Quality LLC es la Solución

Residencial

Comercial

Restauración de Incendios
Microbiología industrial

Control de contaminación, limpieza
de conductos de aire y eliminación de hongo



Cuando se trata de la calidad del aire interior la limpieza de conductos de aire es indispensable. No es sorprendente que sus conductos de aire se ensucien y se obstruyan con el tiempo, especialmente si se toma en cuenta el gran volumen de aire que fluye a través de los mismos diariamente.
Por tal motivo es importante llamar a AGORA’S Indoor Air Quality LLC, los expertos en limpieza de conductos, para una limpieza periódica de los conductos de aire. Los conductos de aire limpios no solo mejoran el flujo de aire sino que también mejoran la calidad del aire, lo cual evita riesgos a la salud.
No permita que los conductos de aire sucios comprometan su comodidad o salud, llámenos ahora para obtener más información sobre nuestra gama de servicios de calidad del aire interior, que siempre están respaldados por nuestra Garantía de servicio profesional.






Llama ahora






